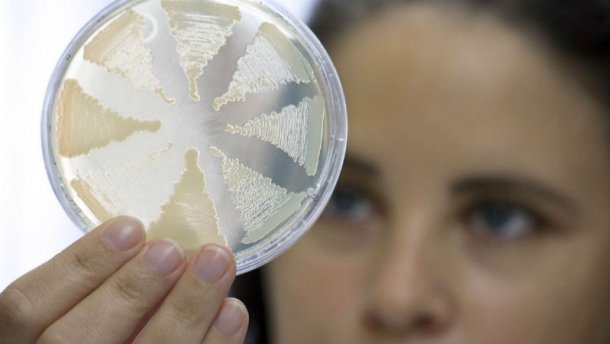
Смертельный ботулизм: в еще одном городе изъяли огромную партию рыбы

Смертельный ботулизм: в еще одном городе изъяли огромную партию рыбы
Смертельный ботулизм: в еще одном городе изъяли огромную партию рыбы
Из супермаркетов Львова изъяли 89 килограммов опасных рыбных продуктов.
Об этом сообщили в областном управлении Госпродпотребслужбы.
"По фактам реализации в торговой сети Львова (супермаркеты "Арсен", "Альянс Маркет") опасной рыбной продукции производства ФЛП Меркулова А.В., с которой связаны случаи заболевания ботулизмом в Киеве, специалистами Госпродпотребслужбы во Львове изъяты из реализации 89 килограммов рыбных продуктов (рыбная стружка вяленого судака, рыбная палочка "Лосось", рыбная палочка "Краковская", вяленый судак, плоскирка, карась вяленый, густера). Рыбная продукция возвращена поставщику", – говорится в сообщении.
В Госпродпотребслужбе просит жителей не покупать в местах стихийной торговли и на агропродовольственных рынках мясные и рыбные продукты домашнего изготовления.
Теги: ГоспотребслужбаРыбаБотулизмЛьвов

Коментарі:
comments powered by DisqusЗагрузка...
Наші опитування
Показати результати опитування
Показати всі опитування на сайті











